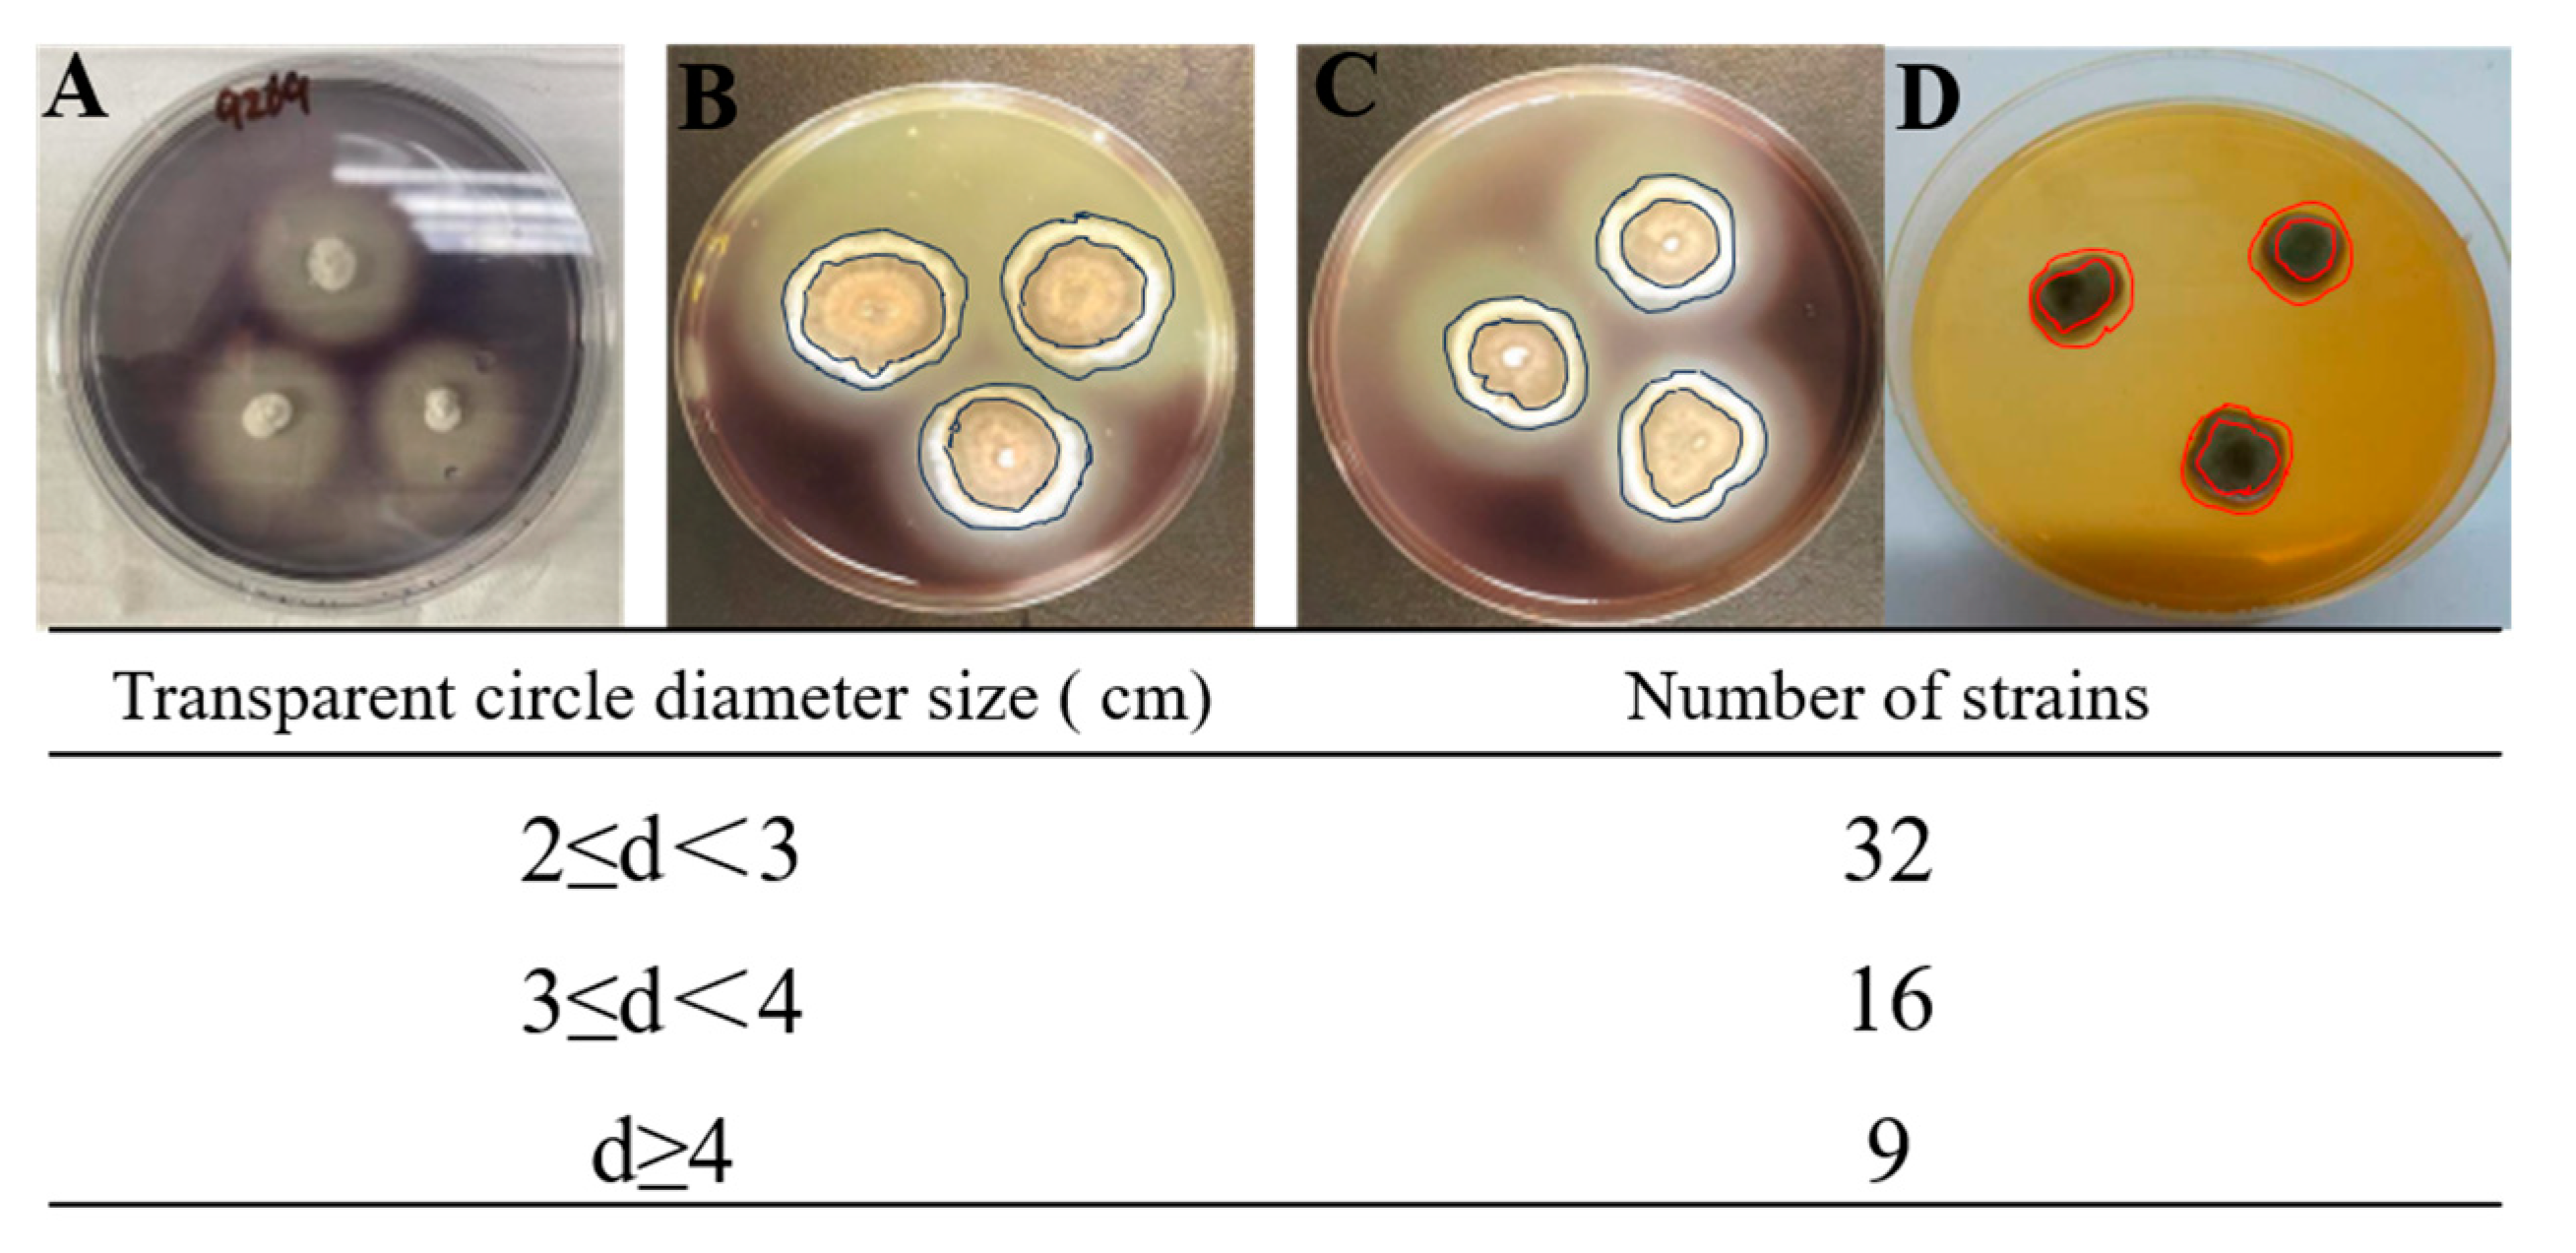

Marine-Derived Fungi as a Valuable Resource for Amylases Activity Screening
Abstract
1. Introduction
2. Material and Methods
2.1. Marine Sediment Samples
2.2. Fungal Isolation
2.3. Visual Screening for Amylotyc Fungi
2.4. Fungi Identification and Phylogenetic Analysis
2.5. Amylase Production and Protein Estimation
2.6. Characterization of Enzyme Stability
3. Results and Discussion
3.1. Fungal Isolation
3.2. Screening for Amylotyc Fungi (Qualitative Determination of Extracellular Enzyme Activity by Visual Plate Assay)
3.3. Characteristics of Cell-Lysate Enzyme Activity (Quantitative Determination of Intracellular Enzyme Activities Spectrophotometrically)
3.4. Effect of pH and Temperature on Amylase Activities of Aspergillus flavus 9261
4. Conclusions
Supplementary Materials
Author Contributions
Funding
Institutional Review Board Statement
Informed Consent Statement
Data Availability Statement
Conflicts of Interest
References
- Beygmoradi, A.; Homaei, A. Marine microbes as a valuable resource for brand new industrial biocatalysts. Biocatal. Agric. Biotechnol. 2017, 11, 131–152. [Google Scholar] [CrossRef]
- Sowell, S.M.; Norbeck, A.D.; Lipton, M.S.; Nicora, C.D.; Callister, S.J.; Smith, R.D. Proteomic analysis of stationary phase in the marine bacterium “Candidatus Pelagibacter ubique”. Appl. Environ. Microbiol. 2017, 74, 4091–4100. [Google Scholar] [CrossRef] [PubMed]
- Bonugli-Santos, R.C.; dos Santos Vasconcelos, M.R.; Passarini, M.R.Z.; Vieira, G.A.L.; Lopes, V.C.P.; Mainardi, P.H.; dos Santos, J.A.; de Azevedo Duarte, L.; Otero, I.V.R.; da Silva Yoshida, A.M.; et al. Marine-derived fungi: Diversity of enzymes and biotechnological applications. Front. Microbiol. 2015, 6, 269. [Google Scholar] [CrossRef] [PubMed]
- Zeng, J.; Guo, J.; Tu, Y.; Yuan, L. Functional study of C-terminal domain of the thermoacidophilic raw starch-hydrolyzing α-amylase Gt-amy. Food Sci. Biotechnol. 2020, 29, 409–418. [Google Scholar] [CrossRef] [PubMed]
- Farias, T.C.; Kawaguti, H.Y.; Koblitz, M.G.B. Microbial amylolytic enzymes in foods: Technological importance of the Bacillus genus. Biocatal. Agric. Biotechnol. 2021, 35, 102054. [Google Scholar] [CrossRef]
- de Eugenio, L.I.; Murguiondo, C.; Galea, S.; Prieto, A.; Barriuso, J. Fungal–lactobacteria consortia and enzymatic catalysis for polylactic acid production. J. Fungi 2023, 9, 342. [Google Scholar] [CrossRef]
- Li, Q.; Wang, G. Diversity of fungal isolates from three Hawaiian marine sponges. Microbiol. Res. 2009, 164, 233–241. [Google Scholar] [CrossRef]
- Osterhage, C. Isolation, Structure Determination and Biologicalactivity Assessment of Secondary Metabolites Frommarine-Derived Fungi. Technischen Universität Carolo-Wilhelmina: Braunschweig, Germany, 2001. [Google Scholar]
- Arifeen, M.Z.U.; Liu, C.-H. Novel enzymes isolated from marine-derived fungi and its potential applications. J. Biotechnol. Bioeng. 2018, 2, 1–12. [Google Scholar]
- Bai, X.F.; Guo, Y.; Kaustubh, B.; Li, C.; Gu, Z.B.; Hu, K. The Global amylase research trend in food science technology: A data-driven analysis. Food Rev. Int. 2021. [Google Scholar] [CrossRef]
- Kikani, B.A.; Singh, S.P. Amylases from thermophilic bacteria: Structure and function relationship. Crit. Rev. Biotechnol. 2021, 3, 325–341. [Google Scholar] [CrossRef]
- El-Kady, E.M.; Asker, M.S.; Hassanein, S.M. Optimization, production, and partial purification of thermostable α-amylase produced by marine Bacterium bacillus sp. NRC12017. Int. J. Pharmaceut. Clin. Res. 2017, 9, 558. [Google Scholar] [CrossRef]
- Mafakher, L.; Ahmadi, Y.; Fard, J.K.; Yazdansetad, S.; Gomari, S.R.; Far, B.E. Alpha-Amylase Immobilization: Methods and Chal lenges. Pharm. Sci. 2022, 2, 144–155. [Google Scholar]
- Wang, Y.C.; Hu, H.F.; Ma, J.W. A novel high maltose-forming a-amylase from Rhizomucor miehei and its application in the food industry. Food Chem. 2020, 305, 125447. [Google Scholar] [CrossRef] [PubMed]
- Paul, J.S.; Dikshit, B.; Santi, L. Aspects and recent trends in microbial α-amylase: A review. Appl. Biochem. Biotechnol. 2021, 193, 2649. [Google Scholar] [CrossRef]
- Farooq, M.A.; Ali, S.; Hassan, A.; Tahir, H.M.; Mumtaz, S.; Mumtaz, S. Biosynthesis and industrial applications of alpha-amylase: A review. Arch. Microbiol. 2021, 4, 1281–1292. [Google Scholar] [CrossRef] [PubMed]
- Abdel-Fattah, Y.R.; Soliman, N.A.; El-Toukhy, N.M. Production, purification, and characterization of thermostable α-Amylase produced by Bacillus licheniformis isolate AI20. J. Chem. 2013, 1, 4615. [Google Scholar]
- Nandy, S.K. Bioprocess technology governs enzyme use and production in industrial biotechnology: An overview. Enz. Engineer. 2016, 5, 1000144. [Google Scholar] [CrossRef]
- Ullah, I.; Khan, M.S.; Khan, S.S. Identification and characterization of thermophilic amylase producing bacterial isolates from the brick kiln soil. Saudi J. Biol. Sci. 2021, 28, 970. [Google Scholar] [CrossRef]
- Zafar, A.; Aftab, M.N.; Iqbal, I. Pilot-scale production of a highly thermostable α-amylase enzyme from Thermotoga petrophila cloned into E. coli and its application as a desizer in textile industry. RSC Adv. 2019, 9, 984. [Google Scholar] [CrossRef]
- Viader, R.P.; Yde, M.; Hartvig, J.W. Optimization of beer brewing by monitoring α-amylase and β-amylase activities during mashing. Baverages 2021, 7, 12. [Google Scholar]
- Liu, H.; Duan, W.-D.; de Souza, F.Z.R.; Liu, L.; Chen, B.-S. Asymmetric ketone reduction by immobilized Rhodotorula mucilaginosa. Catalysts 2018, 8, 165. [Google Scholar] [CrossRef]
- Liu, H.; Chen, B.-S.; de Souza, F.Z.R.; Liu, L. A Comparative study on asymmetric reduction of ketones using the growing and resting cells of marine-derived fungi. Mar. Drugs 2018, 16, 62. [Google Scholar] [CrossRef] [PubMed]
- Liu, H.; de Souza, F.Z.R.; Liu, L.; Chen, B.-S. The use of marine-derived fungi for preparation of enantiomerically pureal cohols. Appl. Microbiol. Biotechnol. 2018, 102, 1317–1330. [Google Scholar] [CrossRef] [PubMed]
- Zeng, Y.-Y.; Yin, X.; Liu, L.; Zhang, W.; Chen, B. Comparative characterization and physiological function of putative fatty acid photodecarboxylases. Mol. Catal. 2022, 532, 112717. [Google Scholar] [CrossRef]
- Yin, X.; Gong, W.; Zhan, Z.; Wei, W.; Li, M.; Jiao, J.; Chen, B.; Liu, L.; Li, W.; Gao, Z. Mining and engineering of valine dehydro genases from a hot spring sediment metagenome for the synthesis of chiral non-natural L-amino acids. Mol. Catal. 2022, 533, 112767. [Google Scholar] [CrossRef]
- Zhang, X.-Y.; Wang, G.-H.; Xu, X.-Y.; Nong, X.-H.; Wang, J.; Amin, M.; Qi, S.-H. Exploring fungal diversity in deep-sea sediments from Okinawa trough using high-throughput Illumina sequencing. Deep-Sea Res. 2016, 116, 99–105. [Google Scholar] [CrossRef]
- Zhang, X.; Zhang, Y.; Xu, X.; Qi, S. Diverse deep-sea fungi from the South China Sea and their antimicrobial activity. Curr. Microbiol. 2013, 67, 525–530. [Google Scholar] [CrossRef]
- Cathrine, S.J.; Raghukumar, C. Anaerobic denitrification in fungi from the coastal marine sediments off Goa, India. Mycol. Res. 2009, 113, 100–109. [Google Scholar] [CrossRef]
- Damare, S.; Raghukumar, C.; Raghukumar, S. Fungi in deep sea sediments of the Central Indian Basin. Deep Sea Res. 2006, 53, 14–27. [Google Scholar] [CrossRef]
- Lowry, O.H.; Rosebrough, N.J.; Farr, A.L.; Randall, R.J. Protein measurement with the Folin phenol reagent. J. Biological Chem. 1951, 193, 265–275. [Google Scholar] [CrossRef]
- Miller, G.L. Use of dinitrosalyicylic acid reagent for determination of reducing sugar. Anal. Chem. 1959, 31, 426–428. [Google Scholar] [CrossRef]
- Beltagy, E.A.; Abouelwafa, A.; Barakat, K.M. Bioethanol production from immobilized amylase produced by marine Aspergillus flavus AUMC 10636. Egypt. J. Aquat. Res. 2022, 48, 325–331. [Google Scholar] [CrossRef]
- Nagano, Y.; Nagahama, T.; Hatada, Y.; Nunoura, T.; Takami, H.; Miyazaki, J.; Takai, K.; Horikoshi, K. Fungal diversity in deep-sea sediments – the presence of novel fungal groups. Fungal Ecol. 2010, 3, 316–325. [Google Scholar] [CrossRef]
- Ali, I.; Akbar, A.; Yanwisetpakdee, B.; Prasongsuk, S.; Lotrakul, P.; Punnapayak, H. Purification, characterization, and potential of saline waste watervremediation of a polyextremophilic α-amylase from an obligate halophilicv Aspergillus gracilis. BioMed Res. Int. 2014, 2014, 106937. [Google Scholar] [CrossRef] [PubMed]
- Ali, E.H.; El-Nagdy, M.A.; Al-Garni, S.M.; Ahmed, M.S.; Rawaa, A.M. Enhancement of alpha amylase production by Aspergillus flavus AUMC 11685 onmandarin (Citrus reticulata) peel using submerged fermentation. Eur. J. Biol. Res. 2017, 7, 154–164. [Google Scholar]

| Fungal Species | Fungal Families | Number of Fungal Isolated | |||||||
|---|---|---|---|---|---|---|---|---|---|
| P1 | P2 | P3 | P4 | P5 | P6 | P7 | P8 | ||
| Aspergillus niger | Trichocomaceae | 2 | 2 | 3 | 1 | 1 | |||
| A. sydowii | Trichocomaceae | 1 | 2 | 1 | 1 | 2 | |||
| A. terreus | Trichocomaceae | 3 | 2 | 4 | 1 | 1 | |||
| A. oryzae | Trichocomaceae | 1 | 1 | 2 | 1 | 1 | |||
| A. tubingensis | Trichocomaceae | 2 | 1 | 2 | 1 | 1 | |||
| A. nomiae | Trichocomaceae | 2 | 1 | 2 | 2 | 1 | 1 | 2 | |
| A. flavus | Trichocomaceae | 2 | 1 | 3 | 1 | 2 | |||
| A. versicolor | Trichocomaceae | 1 | 2 | 1 | 1 | 1 | |||
| A. phoenicis | Trichocomaceae | 1 | 1 | ||||||
| A. westerdijkiae | Trichocomaceae | 2 | 2 | 1 | |||||
| Chaetomium globosum | Chaetomiaceae | 1 | 1 | 1 | |||||
| Cladosporium cladosporioides | Davidiellaceae | 1 | 1 | ||||||
| C. colombiae | Davidiellaceae | 2 | 3 | 3 | 2 | 2 | |||
| C. oxysporum | Davidiellaceae | 2 | 1 | 2 | 1 | 1 | 1 | ||
| C. sphaerospermun | Davidiellaceae | 1 | 1 | 3 | |||||
| C. uredinicola | Davidiellaceae | 3 | 2 | ||||||
| Cyphellophora fusarioides | Cyphellophoraceae | 1 | 2 | 1 | |||||
| Fusarium proliferatum | Nectriaceae | 2 | 3 | ||||||
| F. oxysporum | Nectriaceae | 1 | 2 | 3 | 1 | ||||
| F. nirenbergiae | Nectriaceae | 2 | 2 | 3 | |||||
| F. solani | Nectriaceae | 2 | 1 | 1 | 1 | 1 | |||
| Meyerozyma caribbica | Debaryomycetaceae | 2 | 1 | 1 | 1 | ||||
| Neodeightonia subglobosa | Botryosphaeriaceae | 1 | 2 | 3 | 2 | ||||
| Penicillium aurantiogriseum | Trichocomaceae | 1 | 2 | 2 | 1 | 1 | |||
| P. chrysogenum | Trichocomaceae | 2 | 3 | 3 | 1 | 1 | 1 | 1 | |
| P. album | Trichocomaceae | 2 | 1 | 4 | 3 | 2 | |||
| Saccharomyces cerevisiae | Saccharomycetaceae | 1 | 1 | 2 | 1 | 2 | 1 | ||
| Ochroconis mirabilis | Sympoventuriaceae | 1 | 1 | 1 | 1 | ||||
| Trichobotrys effusa | Pleosporales | 2 | 4 | 1 | |||||
| Total number of fungal isolates | 16 | 41 | 27 | 42 | 29 | 16 | 10 | 18 | |
| Fungi | Activity (U/mg) | Fungi | Activity (U/mg) | Fungi | Activity (U/mg) |
|---|---|---|---|---|---|
| 8070 | 0.0921 ± 0.0001 | 9030 | 0.2790 ± 0.0002 | 9211 | 0.1140 ± 0.0001 |
| 8078 | 0.1571 ± 0.0001 | 9033 | 0.0964 ± 0.0003 | 9222 | 0.0811 ± 0.0002 |
| 8081 | 1.3895 ± 0.0002 | 9048 | 0.0880 ± 0.0001 | 9224 | 0.0533 ± 0.0004 |
| 8083 | 0.1997 ± 0.0001 | 9053 | 0.1793 ± 0.0002 | 9232 | 0.3304 ± 0.0001 |
| 8084 | 0.1777 ± 0.0001 | 9055 | 0.0499 ± 0.0001 | 9244 | 0.1198 ± 0.0001 |
| 8085 | 0.1640 ± 0.0003 | 9060 | 0.1140 ± 0.0003 | 9245 | 0.0262 ± 0.0003 |
| 8087 | 0.1592 ± 0.0002 | 9066 | 0.1146 ± 0.0002 | 9261 | 10.7482 ± 0.0002 |
| 8089 | 0.0447 ± 0.0001 | 9116 | 0.0293 ± 0.0001 | 9263 | 0.5694 ± 0.0001 |
| 8090 | 0.3540 ± 0.0001 | 9171 | 0.6806 ± 0.0003 | 9264 | 0.2164 ± 0.0001 |
| 8094 | 0.2288 ± 0.0002 | 9172 | 0.1606 ± 0.0004 | 9266 | 0.3230 ± 0.0001 |
| 8100 | 0.1365 ± 0.0001 | 9176 | 0.0723 ± 0.0002 | 9267 | 0.4128 ± 0.0002 |
| 8108 | 0.0625 ± 0.0003 | 9177 | 0.2946 ± 0.0005 | 9269 | 0.1125 ± 0.0001 |
| 8911 | 0.0315 ± 0.00002 | 9184 | 0.3517 ± 0.0002 | 9273 | 0.0996 ± 0.0002 |
| 8953 | 0.0874 ± 0.0002 | 9194 | 0.1654 ± 0.0002 | 9277 | 0.1752 ± 0.0001 |
| 8972 | 0.1265 ± 0.0001 | 9197 | 0.1629 ± 0.0003 | 9278 | 0.1430 ± 0.0001 |
| 8975 | 0.1165 ± 0.0001 | 9198 | 0.2528 ± 0.0002 | 9279 | 0.2446 ± 0.0002 |
| 8990 | 0.0423 ± 0.0002 | 9199 | 0.0641 ± 0.0001 | 9288 | 0.2030 ± 0.0003 |
| 9003 | 0.0604 ± 0.0001 | 9201 | 0.1991 ± 0.0001 | 9289 | 0.4982 ± 0.0002 |
| 9029 | 0.1571 ± 0.0002 | 9207 | 0.0668 ± 0.0002 | 9294 | 0.1679 ± 0.0002 |
Disclaimer/Publisher’s Note: The statements, opinions and data contained in all publications are solely those of the individual author(s) and contributor(s) and not of MDPI and/or the editor(s). MDPI and/or the editor(s) disclaim responsibility for any injury to people or property resulting from any ideas, methods, instructions or products referred to in the content. |
© 2023 by the authors. Licensee MDPI, Basel, Switzerland. This article is an open access article distributed under the terms and conditions of the Creative Commons Attribution (CC BY) license (https://creativecommons.org/licenses/by/4.0/).
Share and Cite
Zhang, D.; Liu, L.; Chen, B.-S. Marine-Derived Fungi as a Valuable Resource for Amylases Activity Screening. J. Fungi 2023, 9, 736. https://doi.org/10.3390/jof9070736
Zhang D, Liu L, Chen B-S. Marine-Derived Fungi as a Valuable Resource for Amylases Activity Screening. Journal of Fungi. 2023; 9(7):736. https://doi.org/10.3390/jof9070736
Chicago/Turabian StyleZhang, Di, Lan Liu, and Bi-Shuang Chen. 2023. "Marine-Derived Fungi as a Valuable Resource for Amylases Activity Screening" Journal of Fungi 9, no. 7: 736. https://doi.org/10.3390/jof9070736
APA StyleZhang, D., Liu, L., & Chen, B.-S. (2023). Marine-Derived Fungi as a Valuable Resource for Amylases Activity Screening. Journal of Fungi, 9(7), 736. https://doi.org/10.3390/jof9070736

